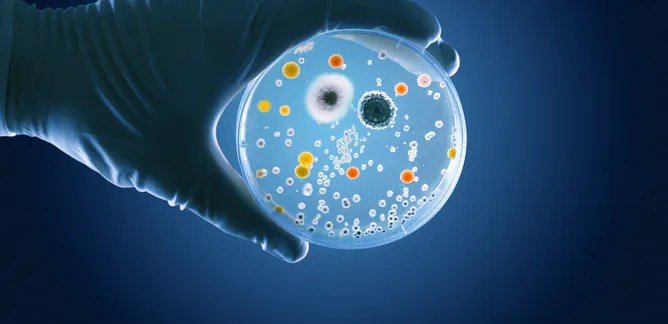
file-20210726-25-1au81j5

MIASTENIA GRAVIS AUTOINMUNE
¿¿ y para cuando ??…¡¡que llevamos 4 SIGLOS esperando!!
El OBJETIVO de la terapia sigue siendo lograr la remisión (inactivación) de la enfermedad. Lo ideal sería una Remisión Total, esto es, poder estar sin medicación y sin síntomas, pero si no pudiera ser, tampoco estaría mal una Remisión Farmacológica, estabilizar la Miastenia con la menor dosis posible de medicación
Actualmente la mayoría de PACIENTES con MIASTENIA realizan su TRATAMIENTO INMUNOSUPRESOR con una doble finalidad:
- Altas dosis de Corticoides que estabilicen con rapidez y eficacia los síntomas miasténicos
- Un Inmunosupresor de mantenimiento (no esteroideo), a largo plazo, que pueda reducir la dosis de los anteriores o suspenderlos por los importantes efectos adversos que generan
…Pero lograrlo no suele ser fácil. Eliminar el Corticoide o reducir su acción a una mínima dosis efectiva así como encontrar el Inmunosupresor eficaz puede convertirse en una tarea médica laboriosa, larga, con cambios farmacológicos, analíticas sanguíneas frecuentes y no exenta de altibajos clínicos, debido a factores propios de la Miastenia (inicio/evolución clínica de la enfermedad, tipos de anticuerpos, presencia de timoma/hiperplasia en la glándula del Timo…) y del paciente (edad, respuesta a la medicación, padecer otras enfermedades…)
El Tratamiento Inmunosupresor debe iniciarse cuando ya hay establecida una Miastenia Generalizada y sus formas son moderadas o severas (algunos profesionales ya lo instauran en la Miastenia Ocular como prevención a su generalización) pues la Terapia Sintomática con Anticolinesterásicos (Mestinón®), que suele ser la 1ª línea del tratamiento, se queda insuficiente al reforzar solo la contracción muscular aumentando la cantidad de acetilcolina y no actuar contra los anticuerpos que bloquean los receptores encargados de la transmisión neuromuscular
Esta terapia con inmunosupresores puede combinarse con otras:
- Tratamiento Inmunomodulador con Inmunoglobulinas intravenosas y Plasmaféresis: utilizadas en Crisis Miasténicas, exacerbaciones agudas de la enfermedad, preparación a la cirugía, como puente mientras se inicia el efecto de los Inmunosupresores (algunos tardan meses en actuar) y como uso periódico en el paciente que está mal controlado y que no responde a la inmunosupresión convencional (Miastenia Refractaria) o no la tolera
- Tratamiento Sintomático con Anticolinesterásicos (Piridostigmina/Mestinón®): como ayuda para la contracción muscular
- Tratamiento Quirúrgico o Timectomía: extirpación quirúrgica de la glándula del Timo, responsable de la producción de anticuerpos contra el «receptor de acetilcolina»
TRATAMIENTO INMUNOSUPRESOR INESPECÍFICO (ESTANDAR)
Es el habitual. Se requiere cuando el paciente aún permanece sintomático con la Piridostigmina (Mestinón®) que es el tratamiento de 1ª línea, o si después de haber estado estabilizado un tiempo con ésta los síntomas vuelven a reaparecer. Aunque está considerado de amplio espectro, es inespecífico y provoca desventajas:
- Inicio lento de la acción
- Más vulnerabilidad a las infecciones
- Efectos adversos sistémicos y mayor toxicidad
- Aumento del riesgo a largo plazo de procesos malignos
El beneficio se obtiene a largo plazo, por lo que deberá ser administrado de manera continuada para ser eficaz
La elección del inmunosupresor habitualmente sigue una “línea de actuación» clásica, con diferentes fármacos (Prednisona, Azatioprina, Micofenolato, Ciclosporina, Tacrólimus, Ciclofosfamida, Rituximab), aunque puede depender de factores como la edad, tolerancia, eficacia o evolución de la enfermedad
Glucocorticoides (Prednisona-Dacortin®)
- Acción con amplio efecto supresor de antígenos y linfocitos-T circulantes

- Controlan los síntomas de forma rápida y eficaz (en semanas)
- Utilizados durante meses, se intentan retirar de forma progresiva. Si vuelven los síntomas o hay efectos adversos importantes se asocia un inmunosupresor (el 1º suele ser la Azatioprina) con la finalidad de ir disminuyéndolos hasta suspenderlos. Esto a veces no es posible por presentarse recaídas, entonces se intenta dejar la mínima dosis efectiva
Azatioprina (Imurel®)
- Antimetabolito. Interfiere en la función de los linfocitos-T impidiendo su división
- Fármaco de elección como «ahorrador de Corticoides». De acción débil y lenta. Se usa sola cuando se ha conseguido retirar la Prednisona, o asociada con ésta a dosis bajas si no ha podido ser retirada
- Su eficacia clínica se logra entre 6 meses y 1 año después de iniciar el tratamiento
Micofenolato (Cellcept®)
- Antimetabolito. Inhibe la proliferación de linfocitos-T y B
- Utilizado cuando la Azatioprina no se tolera bien
- De acción débil. Inicia efecto en 6 meses y el máximo se alcanza en 1-2 años
Metotrexato (Metoject®)
- Antimetabolito. Inhibe la replicación celular
- Uso controvertido como ahorrador de Corticoides. Las guías europeas proponen limitar su uso a pacientes que no responden a las terapias anteriormente mencionadas
Ciclofosfamida (Genoxal®)
- Antimetabolito. Inhibe la actividad de los linfocitos B, y en dosis altas a los linfocitos-T
- Inicia la acción de forma rápida. Experiencia limitada en la Miastenia
- Por su alto riesgo tóxico se recomienda solo para pacientes con Miastenia Refractaria
Ciclosporina (Sandimmun®)
- Inhibidor de la calcineurina. Inactiva los linfocitos-T
- Acción potente y eficaz (en 1 mes) favorecida si se asocia a Corticoides. Efecto máximo en 3-7 meses.
- Indicada cuando la asociación Azatioprina o Micofenolato + Corticoides es ineficaz
Tacrólimus (Prograf®)
- Inhibidor de la calcineurina. Inactiva los linfocitos-T
- Acción rápida (semanas) y efecto máximo en 1-3 meses. Más potente y menos tóxico que la Ciclosporina por su uso a dosis bajas. Puede asociarse con Corticoides
- Se suele indicar cuando la asociación Azatioprina o Micofenolato + Corticoides es ineficaz
Rituximab (MabThera®)
- Anticuerpo monoclonal quimérico murino-humano anti-CD20. Causa agotamiento de los linfocitos-B
- Acción en 1-3 meses
- Habitualmente para la Miastenia Refractaria aunque su uso se ha propuesto como 1ª línea de tratamiento en la Miastenia con «anticuerpos anti-Musk» por lograr tasas altas de remisión y disminuir las recaídas. Utilizado a dosis bajas parece ser efectivo en Miastenia Refractaria con «anticuerpos anti-receptor de acetilcolina»
NUEVAS INMUNOTERAPIAS PARA LA MIASTENIA GRAVIS
– Revisión bibliográfica –


Los nuevos tratamientos que irán apareciendo son prometedores pues la investigación sigue añadiendo nuevos conocimientos sobre el fallo autoinmune en la Miastenia permitiendo desarrollar nuevas terapias mas eficaces y seguras
La mayor parte de estos nuevos fármacos se están utilizando en:
- ENSAYOS CLÍNICOS: estudios para saber si un nuevo tratamiento funciona bien y es seguro
- MIASTENIA EXPERIMENTAL: en animales
- EN OTRAS ENFERMEDADES: Autoinmunes, Cáncer…
Son específicos y van dirigidas contra diferentes elementos del Sistema Inmunológico: Complemento, Receptor del fragmento cristalizable neonatal, Linfocitos-B, Citoquinas, Proteasoma, Linfocitos-T
Tienen ventajas sobre el Tratamiento Inmunosupresor Estandar porque:
- Son «dianas» inmunológicas más selectivas
- Resguardan al resto del sistema inmunológico
- Tienen menor toxicidad y efectos secundarios
- Inician su acción con más rapidez
- Favorecen una Remisión de la Miastenia más duradera
…Pero tampoco están exentas de riesgos (infecciones oportunistas, reactivación de infecciones virales, deterioro inmunológico contra procesos malignos...), por tanto, es esencial una estrecha vigilancia
Inhibidores del Complemento
El COMPLEMENTO es un conjunto de 30 proteínas que reaccionan entre sí generando una importante respuesta inflamatoria
Eculizumab (Soliris®)
- Anticuerpo monoclonal humanizado
- En la Miastenia Refractaria con «anticuerpos antireceptores de acetilcolina»
- Reducción de las exacerbaciones/hospitalización y mejoría clínica. Seguro y eficaz a largo plazo
- Se recomienda la vacuna contra la meningitis 2 semanas antes de iniciarlo y revacunación después de 2-5 años
- Comercializado ya en Europa
Zilucoplan (en fase III)
- Péptido macrólido sintético
- En la Miastenia Refractaria y Miastenia Generalizada moderada/grave con «anticuerpos antireceptores de acetilcolina»
- Administración por vía subcutánea. Mejoría clínica 1 semana después del inicio del tratamiento. Efectos adversos leves
Ravulizumab (en fase III)
- Anticuerpo monoclonal humanizado
- En Miastenia Generalizada
- Se está evaluando su seguridad y eficacia para administrarlo 1 vez cada 15 días
Inhibidores del Receptor de Fc-neonatal (FcRn)
El RECEPTOR DE FC-NEONATAL de Anticuerpos de Inmunoglobulina-G (FcRn) previene el deterioro de los anticuerpos y favorece su reciclaje
Efgartigimod (en fase III y pendiente de aprobación europea en 2023)
- Fragmento de Fc derivado de IgG1 humanizado modificado
- En Miastenia Generalizada con «anticuerpos antireceptores de acetilcolina»
- Mejoría clínica significativa, rapidez/durabilidad en su acción, seguridad y tolerabilidad
- Efectos adversos leves
Nipocalimab (en fase III)
- Anticuerpo monoclonal humano anti-FcRn IgG1 de alta afinidad
- En Miastenia Generalizada con «anticuerpos antireceptores de acetilcolina» o «anti-Musk»
- Probable perfil de seguridad en mujeres embarazadas
- Sin efectos adversos graves ni aumento del riesgo de infecciones
Rozanolixizumab (en fase III)
- Anticuerpo monoclonal humanizado anti FcRn IgG4 de alta afinidad
- En Miastenia Generalizada con «anticuerpos antireceptores de acetilcolina» o «anti-Musk»
- Inyección subcutánea
- Mejoría clínica. La cefalea fue el efecto adverso más frecuente
Batoclimab (fase II completada)
- Anticuerpo monoclonal humanizado anti-FcRn IgG1
- En Miastenia Generalizada con «anticuerpos antireceptores de acetilcolina«
- Inyección subcutánea / intravenosa
- Efectos adversos leves / moderados
RVT-1401 (en fase II)
- Anticuerpo monoclonal humanizado anti-FcRn IgG Total
- En Miastenia Generalizada con «anticuerpos antireceptores de acetilcolina«
- Inyección subcutánea / intravenosa. Efectos adversos leves / moderados
Inhibidores-directos de Linfocitos-B
Los LINFOCITOS-B son células especializadas del sistema inmunológico cuya función principal es reconocer las sustancias que son extrañas para nuestro organismo (antígenos) y producir anticuerpos específicos contra ellas para neutralizarlas
Rituximab (MabThera®) 
- Anticuerpo monoclonal quimérico murino-humano anti-CD20
- (visto anteriormente)
Ocrelizumab (uso en Esclerosis Múltiple)
- Anticuerpo monoclonal humanizado anti-CD20 de 2ª generación
Ofatumumab (en fase III)
- Anticuerpo monoclonal humanizado anti-CD20 de 2ª generación
- Miastenia Generalizada Refractaria
Obinutuzumab (informe de caso)
- Anticuerpo monoclonal humanizado anti-CD20 de 2ª generación
- En Miastenia Generalizada Refractaria y severa
Veltuzumab (estudio en Cáncer Linfático)
- Anticuerpo monoclonal humanizado anti-CD20 de 2ª generación
Inebilizumab (en fase III, uso en Neuromielitis óptica)
- Anticuerpo monoclonal humanizado anti-CD19
- En Miastenia Generalizada con «anticuerpos antireceptor de acetilcolina» o «antiMusk»
Blinatumomab (uso en Cáncer Hematológico)
- Anticuerpo monoclonal biespecífico anti-CD19
Iscalimab (en fase II)
- Anticuerpo monoclonal humano anti-CD40
- En Miastenia Generalizada (moderada / grave) con «anticuerpos antireceptor de acetilcolina» o «antiMusk»
Inhibidores-indirectos de Linfocitos-B
Las CITOQUINAS son un grupo de proteínas que actúan regulando la respuesta inmunológica e inflamatoria. Están asociadas con la producción de anticuerpos: Interleucinas, Factor de necrosis tumoral (factor activador de linfocitos-B), Interferones…
Belimumab (fase II completada)
- Anticuerpo monoclonal recombinante humano IgG1 antifactor BASS (estimulador linfocitos-B)
- No mostró mejoría significativa en Miastenia Generalizada con «anticuerpos antireceptor de acetilcolina» o «anti-Musk»
- Efectos adversos: gripe, náuseas, cefalea, diarrea, dolor espalda
Etanercept (ensayo piloto, uso en Artritis Reumatoide)
- Proteína soluble humana recombinante anti-TNF (factor necrosis tumoral)
- Resultados contradictorios de su beneficio. En 1 ensayo piloto de Miastenia Generalizada con «anticuerpos antireceptor de acetilcolina» y bajos niveles de citoquina IL-6 y de Interferon gamma, se obtuvo mejoría clínica
- Efectos adversos: una paciente con Artritis Reumatoide desarrolló Miastenia Gravis
Adalimumab (uso en Artritis Reumatoide, Psoriasis, Crohn, Uveitis)
- Anticuerpo monoclonal humano recombinante anti-TNFα
- Efectos adversos: una paciente con Artritis Reumatoide desarrolló una Miastenia Gravis Ocular
Infliximab (uso en Artritis Reumatoide, Psoriasis, Crohn, Colitis Ulcerosa)
- Anticuerpo monoclonal quimérico murino-humano recombinante anti-TNFα
Inhibidores del Proteasoma
El PROTEASOMA es un gran conjunto de proteínas que intervienen en la respuesta inmunológica y en los mecanismos de tolerancia autoinmune
Bortezomib (en Miastenia Experimental, en fase II, uso en Mieloma)
- Dipéptido inhibidor del proteasoma
- En Miastenia Refractaria con «anticuerpos antireceptores de acetilcolina» o «antiMusk»
- En animales redujo eficazmente los anticuerpos antireceptores de acetilcolina y disminuyó los síntomas miasténicos
- Un paciente con Miastenia Refractaria con «anticuerpos antiMusk» obtuvo una mejoría moderada
- Efecto adverso: polineuropatía, reactivación de infección por virus herpes
ONX 0914 (en Miastenia Experimental)
- Inhibidor selectivo del inmunoproteasoma
- En Miastenia Generalizada con «anticuerpos antireceptores de acetilcolina» redujo la gravedad en animales al inhibir la afinidad del anticuerpo y disminuir los niveles de células implicadas en la autoinmunidad
Regulación o Inhibición de Linfocitos-T
Los LINFOCITOS-T son células especializadas del sistema inmunológico que al madurar en el Timo adquieren un receptor mediante el cual identifican específicamente al antígeno (bacterias, virus, toxinas…). Su alteración, y la sobreactivación a través de citoquinas de linfocitos-T colaboradores (Th1, Th2 y TFh) son los principales factores en el mecanismo de acción y evolución de la Miastenia
Secukinumab (uso en Psoriasis, estudio en Espondilitis Anquilosante)
- Anticuerpo monoclonal humano anti-interleucina IL-17A (citoquina)
Rontalizumab (estudio en Lupus Eritematoso Sistémico)
- Anticuerpo monoclonal humanizado anti-interferón alfa (citoquina)
Tocilizumab (informe de caso, uso en Artritis Reumatoide)
- Anticuerpo monoclonal recombinante humanizado anti-interleucina IL-6
- En Miastenia Refractaria con «anticuerpos antireceptores de acetilcolina»
- Mejoría clínica en pocos meses
Abatacept (en fase I, uso en Artritis Reumatoide/Psoriásica)
- Proteina de fusión recombinante
- En Miastenia Refractaria
Terapia con Linfocitos-T (células CAR-T)
Terapia con Células CAR-T (en fase I y II)
- Está protagonizando una nueva era en el campo de la Inmunoterapia
- Consiste en extraer los Linfocitos-T de la sangre del paciente y modificarlos en laboratorio con un gen especial llamado receptor de antígeno quimérico (CAR-T) para que se unan a las células cancerosas
- Se ha aprobado en algunas neoplasias hematológicas (leucemia, linfoma, mieloma)
- Su principal obstáculo es el Síndrome de liberación o tormenta de citoquinas, una potente respuesta inmunológica que puede causar un grave trastorno orgánico
Terapia con Células CAAR-T
- Se está desarrollando experimentalmente en algunas enfermedades autoinmunes (pénfigo, lupus, encefalomielitis)
- Se basa en reestructurar el anterior tratamiento con células del receptor T de autoanticuerpos quiméricos (CAAR-T) para eliminar a los linfocitos-B productores de anticuerpos
- Puede ser una estrategia eficaz en enfermedades autoinmunes y ofrecer un tratamiento novedoso en la Miastenia Gravis
Trasplante de Células Madre Hematopoyéticas (TCMH)
(serie de casos retrospectiva, en fase II)
Se basa en la idea de que las células inmunes trasplantadas se “reiniciarán” quedando libres de la reactividad autoinmune. Su acción es eliminar durante la fase de acondicionamiento (con terapia citotóxica o radiación) la función autorreactiva de los Linfocitos-T y Linfocitos-B existentes. El TCMH mejora la inmunotolerancia y reduce los autoanticuerpos
- En Miastenia Generalizada Refractaria
- Todos los pacientes se encontraban en remisión completa estable en un seguimiento de 40 meses. A los 8 meses del TCMH los pacientes habían interrumpido los Inmunosupresores
- Remisión prolongada y completa sin síntomas y sin tratamiento
- Las complicaciones fueron transitorias y ningún paciente ingresó en UCI
- Puede ser en un futuro una opción de tratamiento en la Miastenia resistente al tratamiento
Vacunas
(en Miastenia Experimental)
- De Péptidos de Receptor de Acetilcolina (mucosa del receptor) por vía oral o nasal. Efecto adverso: potencial exacerbación de la Miastenia
- De ADN. Efecto adverso: potencial exacerbación de la Miastenia
- De Dominios Citoplasmáticos de Receptor de Acetilcolina en adyuvante (músculo humano expresado en bacterias). Reciente y prometedora como enfoque terapéutico específico, seguro, potente, eficaz, de acción rápida y duradera para la Miastenia

BIBLIOGRAFÍA
-
-
Lascano AM, Lalive PH. (2021). Update in immunosuppressive therapy of myasthenia gravis. Autoimmun Rev. 20(1):102712 doi: 10.1016/j.autrev.2020.102712 https://www.sciencedirect.com/science/article/pii/S1568997220302913?via%3Dihub
- Rodolico, C., Nicocia, G., Damato, V., Antonini, G., Liguori, R., & Evoli, A. (2021). Benefit and danger from immunotherapy in myasthenia gravis. Neurological sciences : official journal of the Italian Neurological Society and of the Italian Society of Clinical Neurophysiology, 42(4), 1367–1375. https://doi.org/10.1007/s10072-021-05077-6
-
-
- Menon, D., Barnett, C., & Bril, V. (2020). Novel Treatments in Myasthenia Gravis. Frontiers in neurology, 11, 538. https://doi.org/10.3389/fneur.2020.00538
-
- Cai, X.-J., Li, Z.-W., Xi, J.-Y., Song, H.-Z., Liu, J., Zhu, W.-H., Guo, Y. and Jiao, Z. (2019), Myasthenia gravis and specific immunotherapy: monoclonal antibodies. Ann. N.Y. Acad. Sci., 1452: 18-33. https://doi.org/10.1111/nyas.14195
-
- Alabbad S, AlGaeed M, Sikorski P, Kaminski HJ. Monoclonal Antibody-Based Therapies for Myasthenia Gravis. BioDrugs. 2020 Oct;34(5):557-566. http://dx.doi.org/10.1007/s40259-020-00443-w
-
- Albazli K, Kaminski HJ, Howard JF Jr (2020) Complement inhibitor therapy for myasthenia gravis. Front Immunol 11:917. https://doi.org/10.3389/fimmu.2020.00917
-
- Beecher G, Putko BN, Wagner AN, Siddiqi ZA. Therapies Directed Against B-Cells and Downstream Effectors in Generalized Autoimmune Myasthenia Gravis: Current Status. Drugs. 2019 Mar;79(4):353-364. 10.1007/s40265-019-1065-0
-
- Wang, S., Breskovska, I., Gandhy, S., Punga, A. R., Guptill, J. T., & Kaminski, H. J. (2018). Advances in autoimmune myasthenia gravis management. Expert review of neurotherapeutics, 18(7), 573–588. https://doi.org/10.1080/14737175.2018.1491310
-
- Muppidi S, Utsugisawa K, Benatar M et al (2019) Long-term safety and efficacy of eculizumab in generalized myasthenia gravis. Muscle Nerve 60:14–24 https://doi.org/10.1002/mus.26447
-
- Sanders, D.B., Wolfe, G.I., Benatar, M., Evoli, A., Gilhus, N.E., Illa, I…Narayanaswami, P. (2016). International consensus guidance for management of myasthenia gravis: Executive summary. Neurology. 87(4), 419-425. https://dx.doi.org/10.1212/WNL.0000000000002790
-
- Huda R. (2020). New Approaches to Targeting B Cells for Myasthenia Gravis Therapy. Frontiers in immunology, 11, 240. https://doi.org/10.3389/fimmu.2020.00240
-
- Mantegazza, R., & Antozzi, C. (2020). From Traditional to Targeted Immunotherapy in Myasthenia Gravis: Prospects for Research. Frontiers in neurology, 11, 981. https://doi.org/10.3389/fneur.2020.00981
-
- Hehir MK, Hobson-Webb LD, Benatar M, Barnett C, Silvestri NJ, Howard JF Jr, Howard D, Visser A, Crum BA, Nowak R, Beekman R, Kumar A, Ruzhansky K, Chen IA, Polea MT, LaBoy SM , Fellman MA, Greene SM, Pasnoor M, Burns TM (2017) Rituximab como tratamiento para la miastenia gravis anti-MuSK: revisión prospectiva multicéntrica ciega. Neurología. 89 (10): 1069–1077. https://doi.org/10.1212/WNL.0000000000004341
-
- Binks S, Vincent A, Palace J. Myasthenia gravis: a clinical-immunological update. J Neurol. 2016 Apr;263(4):826-34. https://dx.doi.org/10.1007/s00415-015-7963-5
-
- Habib AA, Ahmadi Jazi G, Mozaffar T. Update on immune-mediated therapies for myasthenia gravis. Muscle Nerve. 2020 https://doi.org/10.1002/mus.26919
-
- Nguyen-Cao TM, Gelinas D, Griffin R, Mondou E. Myasthenia gravis: historical achievements and the “golden age” of clinical trials. J Neurol Sci. 2019;406:116428 https://doi.org/10.1016/j.jns.2019.116428
-
- Guptill, J. T., Soni, M., & Meriggioli, M. N. (2016). Current Treatment, Emerging Translational Therapies, and New Therapeutic Targets for Autoimmune Myasthenia Gravis. Neurotherapeutics : the journal of the American Society for Experimental NeuroTherapeutics, 13(1), 118–131. https://doi.org/10.1007/s13311-015-0398-y
-
- https://miasteniaysalud.com/inmunoterapias-cronicas/ (acceso el 07/oct/2021)
-
- https://miasteniaysalud.com/conocer-los-tratamientos/ (acceso el 07/oct/2021)






Muchísimas gracias, Antonio. Menudo trabajazo has hecho. No tenía ni idea de que había tantos caminos abiertos ¡Ojalá pronto lo veamos y disfrutemos!
Me gustaMe gusta
Gracias Marta…ojalá lo veamos…saludos
Me gustaMe gusta
Muchisimas Gracias
Me gustaMe gusta
Muchas gracias por toda la información y actualización de manejo de tratamiento que al parecer serán prometedores y de un mejor manejo de pacientes mi asténicos , lo que influirá en una mayor calidad de vida , control y manejo de la enfermedad
Actualmente me han realizado la timectomia y me siento con una buena evolución clínica
Espero seguir teniendo información actualizada sobre esta enfermedad.
muchas gracias .
Me gustaMe gusta
Pingback: Nuevo tratamientos, nuevas esperanzas. – Miastenia Gravis – Asturias
Buenos dias
Gracias por tu estupendo blog, que me lleva años ayudando a llevar esta enfermedad .
Es magnifica la información que compartes. Información mas completa que la que me han proporcionado en mis numerosas visitas a Neurólogos y Urgencias de hospitales . Enfermedad muy desconocida en estas ultimas (siempre voy con mi historial impreso a ellas)
Realmente , haces un trabajo incomiable
Un fuerte abrazo
Me gustaMe gusta
muchas gracias Javier por tu comentario…mi objetivo es siempre ayudar a sobrellevar esta complicada enfermedad…otro abrazo fuerte para ti
Me gustaMe gusta